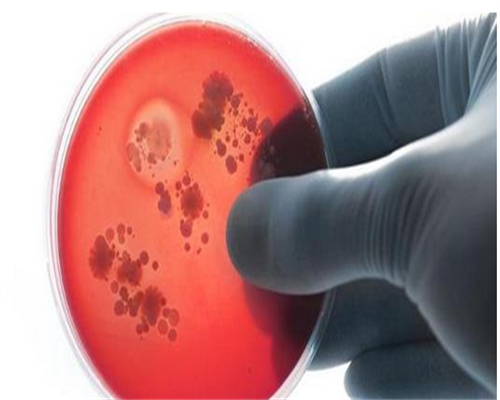
冻卵复苏后和新鲜卵子一样吗？冻卵做试管成功率高吗？

冻卵复苏后和新鲜卵子一样吗?冻卵做试管成功率高吗?
来源:http://www.bgthkds.com 作者:创博生殖中心 发布时间:2025-11-08
摘要:
| 冻卵复苏后和新鲜卵子一样吗?冻卵做试管成功率高吗?如果复苏冻卵过程中,操作手法不对,或实验室条件不达标,导致卵子受损,可能会影响其与精子的结合,即合成的胚胎达不到移植标准。而这个时候,则要重新促排取卵。 冻卵复苏后和新鲜卵子一样吗
女性有冻卵后可不可以直接做试管婴儿要看情况,具体如下:
1、如果卵子解冻后质量仍然比较好,能和精子结合发育成优质胚胎,那么可不用再次促排,直接做试管婴儿就行;
2、若是医生认为解冻后的卵子活性不够,可能需要重新促排取卵,不然试管成功率会很低。
由于卵子冷冻技术仍在发展阶段,对医生的技术和设备要求较高,卵子解冻后的质量无法保证,而且和新鲜卵子有一定区别,所以冻卵解冻移植有一定风险,建议考虑清楚再做。不过也不用太担心,如果是在正规医院冻卵,发生失误的概率相对较低。
试管冻卵有成功怀孕的吗
从世界范围来看,试管冻卵成功怀孕的人还是比较多的,由于国外对冻卵的限制较少,所以很多女性都会选择将卵子进行冷冻,然后挑选合适的时机做试管婴儿。
虽然冷冻卵子比冷冻胚胎解冻后让女性怀孕的几率要低许多,而且技术难度很大,不过近年来试管婴儿技术在不断革新,很多难题都被攻克了。
冻卵做试管成功率高吗
冻卵做试管成功率高不高是因人而异的,因为每个女性的体质不一样,卵子、精子、胚胎的质量存在较大差异,所以目前没有准确的数据。
冻卵复苏后和新鲜卵子一样吗?冻卵做试管成功率高吗?不过据不完全统计,如果各方面条件都满足要求的话,成功率可达50%-60%左右,若是子宫环境和胚胎质量都一般的话,成功率可能只有30%-40%,不过具体以实际为准。 |